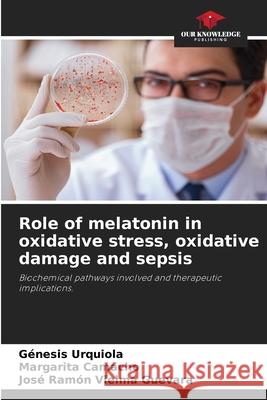
Role of melatonin in oxidative stress, oxidative damage and sepsis Urquiola, Génesis, Camacho, Margarita, Vielma Guevara, José Ramón 9786208687625 Our Knowledge Publishing - książka

Role of melatonin in oxidative stress, oxidative damage and sepsis » książka
Role of melatonin in oxidative stress, oxidative damage and sepsis
ISBN-13: 9786208687625 / Angielski / Miękka / 2025 / 64 str.
To describe the general concepts of free radicals, oxidative stress, oxidative damage and the evidence obtained in in vivo and in vitro models on the potential use of melatonin in different bacterial infections (Gram positive and Gram negative) and the development of sepsis, we performed a qualitative systematic review with information validation criteria, with the use of seven search engines, meta-search engines and databases: Google Scholar, WebMD, Trip, Medscape, PubMed, NICE, and Scielo, which resulted in the retrieval of 380.792 documents using a combination of keywords in English and Spanish and the use of Boolean operators: AND, OR or NOT. The complexity of the pathophysiology of different bacterial infections and sepsis allowed us to infer that there is cross-talk between oxidative stress, oxidative damage, antioxidant activity, innate immunity and mitochondria. The analysis of the evidence allowed us to point out that melatonin acts as an anti-inflammatory through the Nuclear Factor Kappa Beta and NLRP3 inflammasome pathways; in addition to its properties as a free radical scavenger.